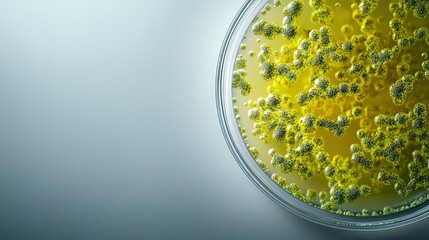
Macroscopic View of Bacterial Colonies in Petri Dish
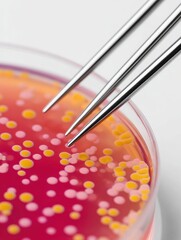
Close-up of laboratory tweezers picking colorful bacterial colonies in a petri dish

-
Obrazy
> - Obrazy do salonu
- Obrazy do sypialni
- Obrazy na szkle
- Obrazy ręcznie malowane
- Obrazy abstrakcyjne
- Obrazy z kwiatami
- Obrazy z mapami
- Obrazy z miastami
- Obrazy z pejzażami
- Obrazy religijne
- Obrazy Banksy
- Obrazy na wymiar
- Obrazy do kuchni
- Obrazy do łazienki
- Obrazy dla dzieci
- Obrazy w ramie
- Obrazy 3D
- Obrazy okrągłe
- Obrazy do biura
- Duże obrazy
- Obrazy czarno-białe
- Fotoobrazy ze zdjęcia
- Obrazy na płótnie bawełnianym
- Galeria
- Obrazy reprodukcje
-
Fototapety
> - Fototapety autorskie
- Fototapety do salonu
- Fototapety do sypialni
- Fototapety samoprzylepne
- Fototapety do kuchni
- Fototapety 3D
- Fototapety dla dzieci
- Fototapety kwiaty
- Fototapety z górami
- Fototapety z lasem
- Fototapety mapy świata
- Fototapety do łazienki
- Fototapety kosmos
- Fototapety czarno białe
- Fototapety liście
- Fototapety na klatkę schodową
- Fototapety okrągłe
- Fototapety tła i desenie
- Fototapety graffiti
- Fototapety abstrakcyjne
- Fototapety wodoodporne
- Fototapety pejzaże
- Fototapety dla chłopca
- Fototapety dla dziewczynki
- Fototapety XXL
-
Tapety
> -
Plakaty
> -
Parawany
> - Galeria
- Propozycje
- Nowości
-
Pozostałe
> -
Zamów z własnego zdjęcia
>
Skorzystaj z oferty 10% taniej! koniec promocji za: 09:37:54
Opinie naszych klientów
★★★★★
Szybka realizacja
Bardzo szybko zamówienie zostało zrealizowane. Przesyłka w cenie! Super
Stacja Circlek, Magdalena Gęsieniec
★★★★★
Polecam
Polecam - Bardzo dobry kontakt z właścicielem - doradztwo profesjonalne i pomoc przy wyborze fototapety 3D
Andrzej Sielski
★★★★★
Jestem zachwycona
Wszystko sprawnie, szybko i w wysokiej jakości. Polecam bardzo serdecznie.
Sandra Piorun
★★★★★
Polecam…pełen profesjonalizm?
Polecam…pełen profesjonalizm?
Paweł Paciora
ZAKUPY
NA RYNKU
ZAUFANIA
NA ZWROT
REALIZACJA